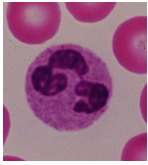

| 메뉴 ID | 7 |
| 메뉴 이름 | 면역세포 |
| 전체 이름 | |
| 깊이 | 1 |
| 순서 | 36 |
| 타입 | 컨텐츠 |
| 사용 여부 | 사용 |
| 페이지 여부 | 페이지 |
| 타겟 | _self |
| 조회수 | 6,174 |
| 등록일 | 2016-03-11 18:05:05 |
| 수정일 | 2016-03-11 18:05:05 |
원본 파일명: 2016/160216154320337546.jpg

1. 대식세포(macrophage)
대식세포는 주로 조직에 존재하는
단핵 탐식세포이며,
대식세포가 성숙하기 전 혈액을 순환하는 상태일 경
우 단핵세포(monocyte)라고 부른다(그림2-4)
골수에서 발생하는 조혈작용에 의해 생성된 과립세포
-단핵세포의 전구세포는 전단핵세포(promonocyte)
로 분화한후 골수를 떠나 혈액으로 이동하고, 이후 혈
액에서 단핵세포로 분화한다.
혈액에서 약 8시간 정도 순환하며 단핵세포는 크기가
커지게 되고, 이후 조직으로 이동하여 조직특이적인
대식세포로 분화한다.
대식세포는 연결조직, 위장관 점막하층, 폐, 간, 신장
뇌, 뼈등 인체의 전신에 걸쳐 폭넓게 존재하며, 세포
가 분포되어 있는 위치에 따라서 각각 조직구
(histiocyte), 장대식세포, 폐포대식세포, 쿠퍼세포
(kupffer cell), 사구체간질세포, 소교세포(microglial cell), 파골세포등의 이름으로 불린다.
활성화된 대식세포에서는
탐식활성, 미생물사멸능력, 염증매개물질분비, T세포활성화에 의한 영향이 크게 증가하므로 휴지기 때에 비하여 더욱 효과적으로 병원균을 제거할 수 있다. 또한 휴지기 때와는 달리 활성화된 대식세포는 다양한 세포독성 단백질을 분비하여 바이러스 감염세포, 종양세포, 세포내 감염된 세균등 여러종류의 항원표적을 제거한다.
대식세포는 외래성 항원인 모든 미생물과 불용성 입자들을 탐식하고 소화하는 것은 물론
손상되거나 죽은 인체의 세포, 세포의 잔해, 활성화된 혈액응고인자등 내생성 물질 역시
탐식하여 소화할 수 있다.
탐식작용은 대식세포의 세포막에 항원이 부착하는 것으로부터 시작된다(그림 2-5)

2. NK(Natural Killer Cell)세포

가. NK세포와 항노화(Anti-aging)
2013년 영국의 한 대학연구실에서 발표한 연구논문에 의하면 나이든 사람의
nk세포는 활성도가 떨어져 있으며, 퍼포린, 그랜자임분비에 의한 독성도 약해지고
싸이토카인의 분비성도 떨어진다고 보고하고 있다.
NK세포는 우리몸을 방어하는 최전선에 있는 면역세포이다.
NK세포의 기능이 떨어져 외부로부터 생체로 유입되는 항원에 제대로 대응하지 못하면
생체기능이 약화되어 몸에 기력이 떨어지면서 노화가 촉진되는 원인이 된다.
NK세포와 같은 면역세포를 잘 유지하고, 활성화 시키는 것은
노화를 방지하고 내 몸의 건강을 지키는 중요한 일 이다.
나. NK(Natural Killer cell)세포의 기능

NK세포는 선천적인 면역을 담당하는 혈액속 백혈구의 일종으로, 간과 골수에서
성숙한다. 일명 “자연살해세포”라고도 한다
바이러스에 감염된 세포나 암세포를 직접 공격해 없애는 것이 NK세포의 주 기능이다.
바이러스에 감염된세포나 암세포는 다른 세포와 달리 세포 표면에 특정단백질(MHC Class 1)이 적어지는 것 등의 이상이 생기는데, NK세포는 이 이상을 감지해 바이러스에 감염된 세포나 암세포를 인지해 공격한다.
이때 퍼포린(Perforin)을 분비해 감염세포나 암세포의 세포막에 구멍을 내고, 여기에
그랜자임(Granzyme)을 내어 이 세포들을 사멸시킨다
이밖에 다른 면역세포의 증식을 유도하는 등의 역할을 하는 면역반응을 일으키는
물질인 케모카인(Chemokine)과 사이토카인(Cytokine)을 분비할 수도 있다
특히 NK세포가 암세포를 공격해 암세포의 발생과 증식, 전이를 막는다는 것 외에도
암이 재발하는데 가장 중요한 역할을 하는 암 줄기세포를 효과적으로 제어 할 수 있다.
3. 수지상세포 (dendritic cell)
• 세포 돌기 (dendrite)를 가지고 있는 세포
• T cell에 항원을 제시하는 주요 세포
: MHC의 발현
• 대부분 골수의 전구세포가 골수에서 분화 성숙

4. 임파구 (lymphocytes)
• 골수에서 혈구줄기세포가 성숙되어 만들어진다
• 항원을 만나기 전의 임프구 (resting lymphocytes)
: 작은 임프구 (small lymphocytes)
: 커다란 핵을 가진 8-10μm정도 크기의 세포
• 항원에 의하여 활성화되어 활성화된 임프구로 전환 (activated lymphocytes)
: 증식 및 분화

(1) 임파구의 종류

• B 임프구 (B lymphocytes)
: 항체의 생산
• T 임프구 (T lymphocytes)
: 흉선 (thymus)에서 성숙
: 면역 반응의 조절 및 작용
- helper T cell (도와주는 T 임프구)
- cytotoxic T cell (세포독성 T 임프구)
- regulatory T cell (조절 T 임프구)
• NK세포(Natural Killer,NK Cell)
: 자연면역계 임파구
: 암세포나 바이러스에 감염된 세포살해.

(2) blast transformation과 임프구아세포(lymphoblast)
• 임프구는 항원에 의해 활성화될 때, 모양이 변하면서 분열한다
: 항원은 resting lymphocyte를 cell cycle의 G1 단계로 들어가게 한다
: 세포가 커지고, 세포질이 많아지며, 전사가 증가되고, 분열하게 된다
• blast transformation의 결과 림프구는 증식하고 분화한다
: 작용세포의 분화
: 기억세포로의 전환

(3) 림프구 활성화와 항원의 역할
• 각각의 항원은 항원과 반응하는 특정한 림프구만을 활성화시킨다
: mono- 또는 oligo- clonal activator
• polyclonal activator (다클론활성화인자)
: lectins 또는 super antigen
: conA, Staphycoccal enterotoxins, LPS

5. 과립세포(granular cell)
• 세포질에 과립 구조물이 많이 있는 백혈구 (granular leukocytes)
: 염증반응의 작용세포 (inflammatory cell)
: 미생물이나 죽은 세포를 제거
• 골수의 전구세포가 골수에서 분화 성숙
: 호중구, 호염구, 호산구

(1) 호중구 (neutrophil)
• 여러개의 자루모양 (multilobed)의 형태가 일정하지 않은 핵
: polymorphonuclear (PMN) leukocyte
• 자연면역의 주요한 식균세포로 급성 염증 반응
• 항체에 의하여 opsonization 기능을 보여주는 세포

(2) 호산구 (eosinophil)
• 바이러스감염, 알러지 반응, 기생충감염 등에서 항원을 제거하는 기능

(3) 호염구 (basophil)
• 높은 친화력의 IgE receptor를 가지고 있는 세포
• 알러지 반응을 시작하게 하는 세포
: 급성과민반응 (immediate type hypersensitivity, allergy)
